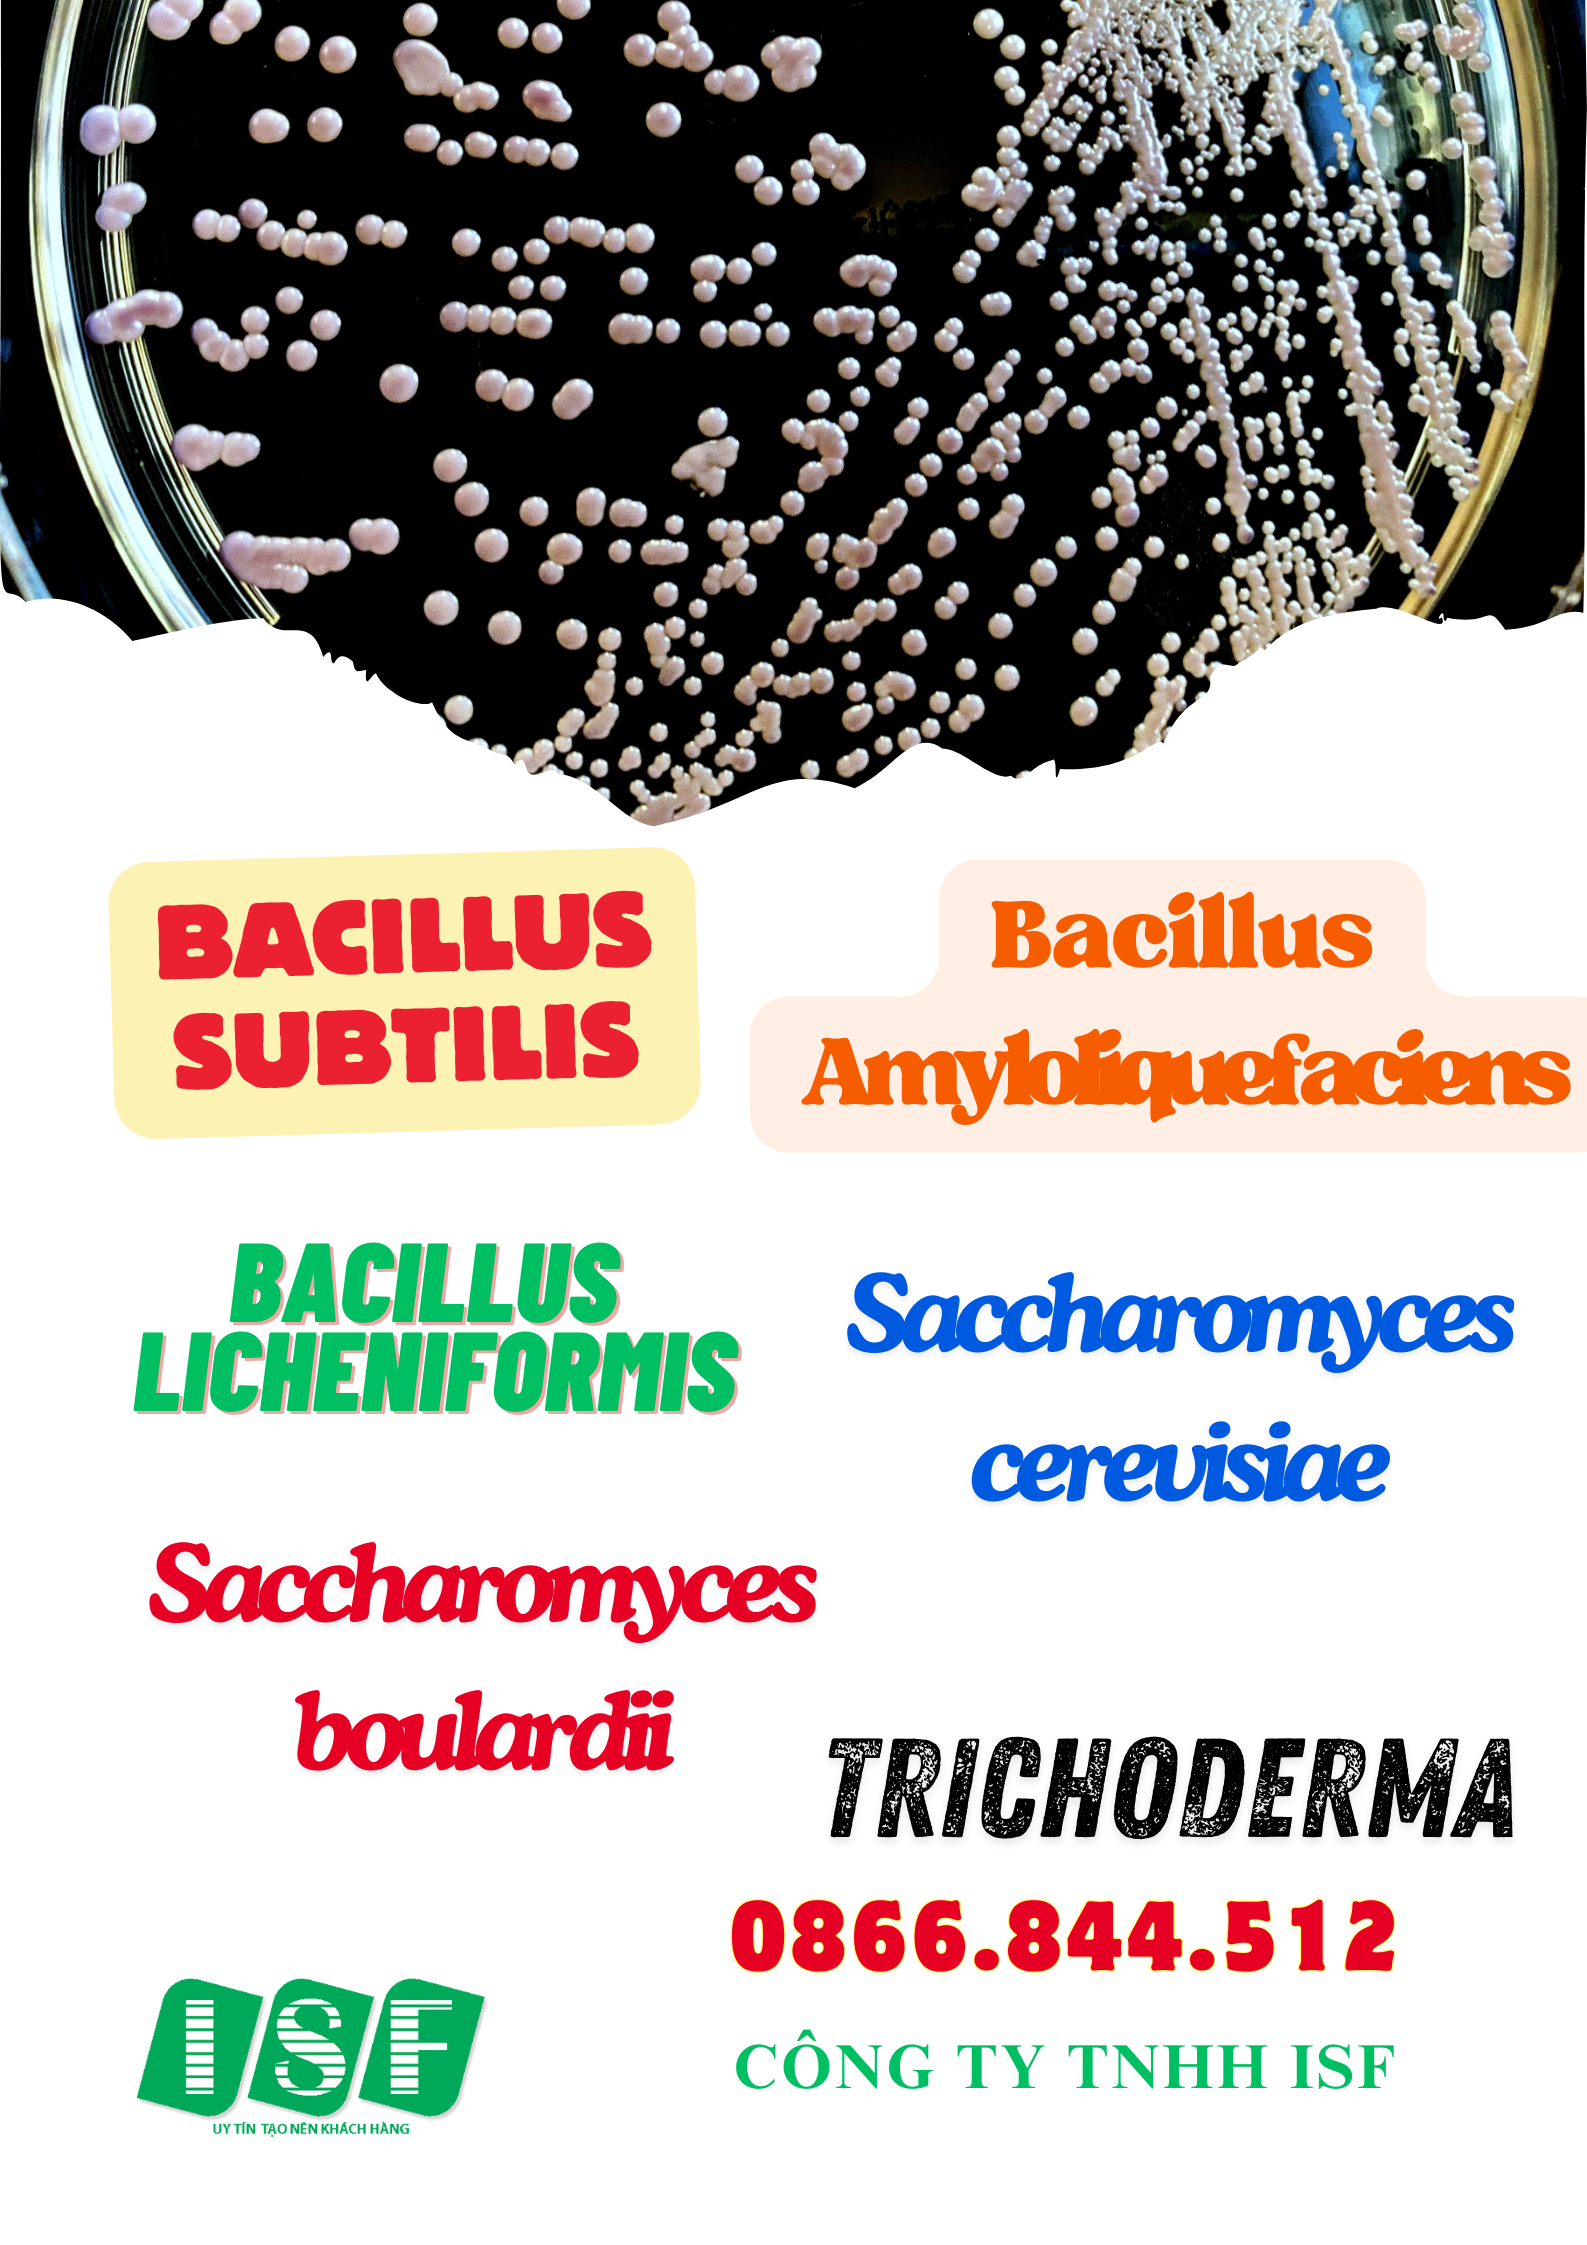

Men Saccharomyces cerevisiae dạng bột tiêu hóa tốt cho vật nuôi.
Men vi sinh tự nhiên thay thế cho kháng sinh.
Tăng cường tiêu hóa, giảm thời gian hấp thụ thức ăn
Trị tiêu chảy do vi sinh đường ruột.
Chủng SACCHAROMYCES CEREVISIAE chịu được pH thấp trong dạ dày, tác động của muối
mật.
Nồng độ: 20 tỷ men sống/g ( 2 x1010 cfu/g).
Trộn trực tiếp vào cám.
1-2kg/ 1 Tấn thức ăn thủy sản.
500-1kg/ 1 tấn thức ăn chăn nuôi.
Đóng gói và bảo quản
Thùng 10kg gọi hotline 0866.844.512.